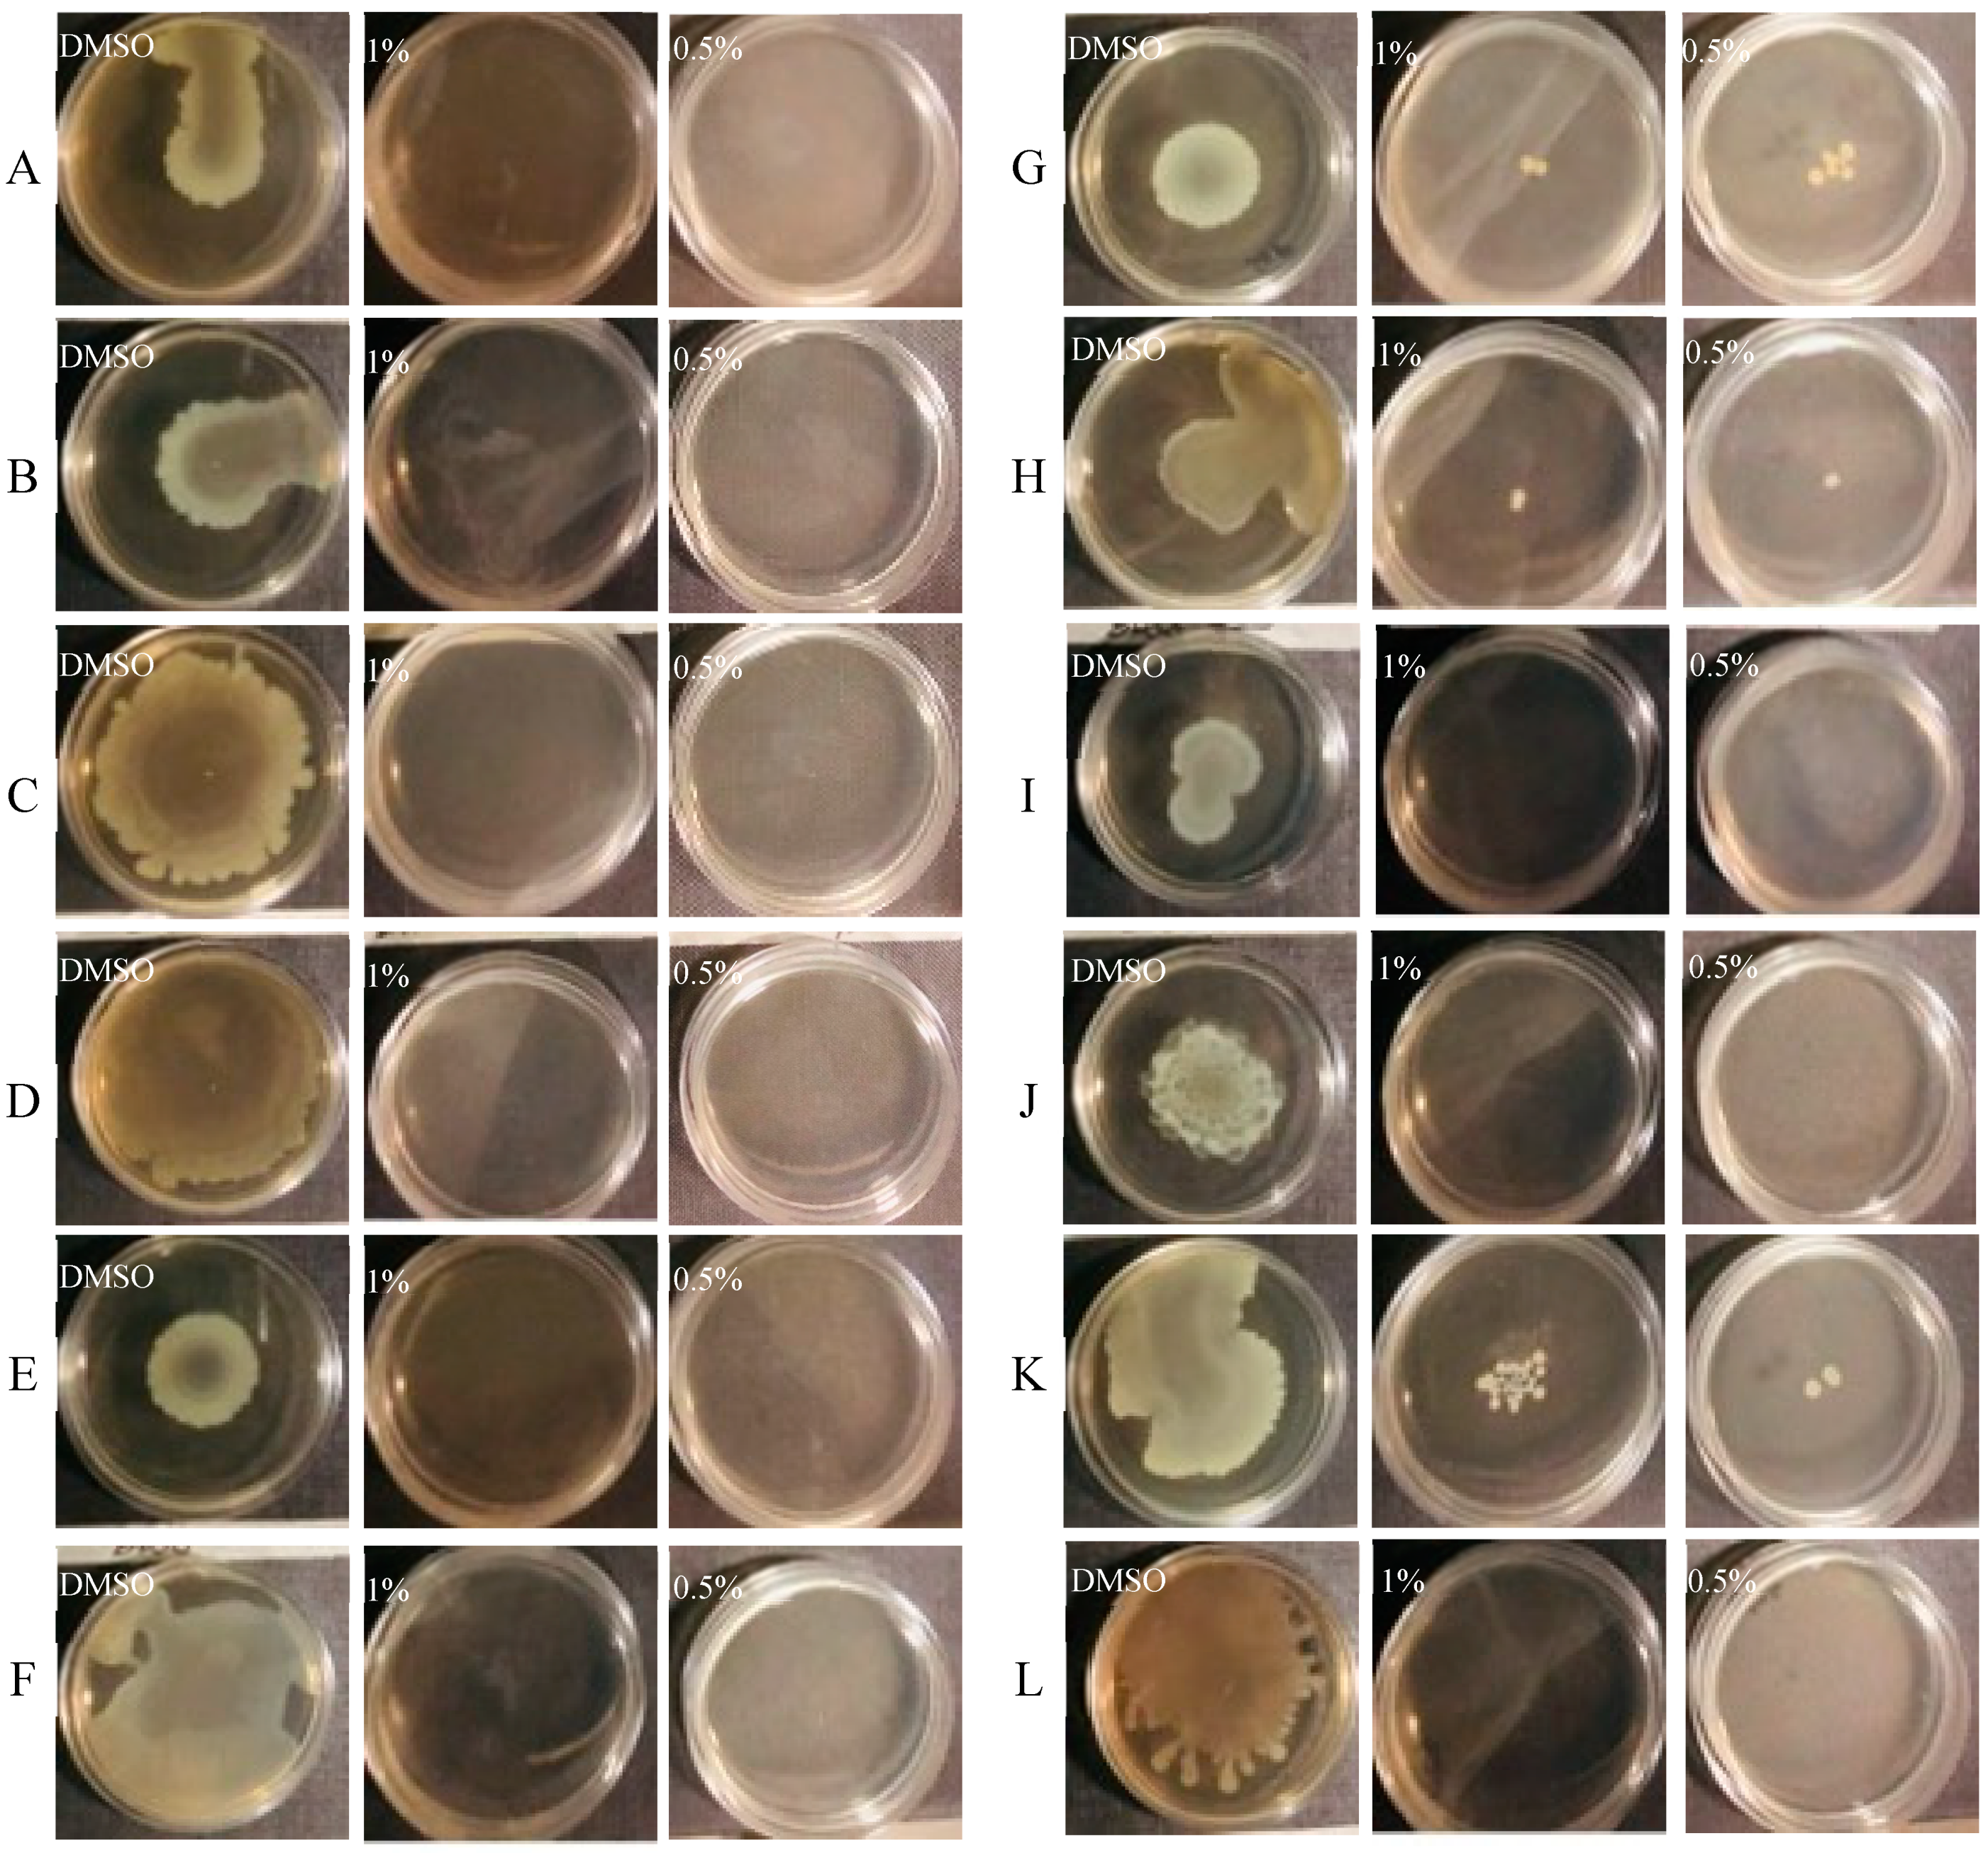
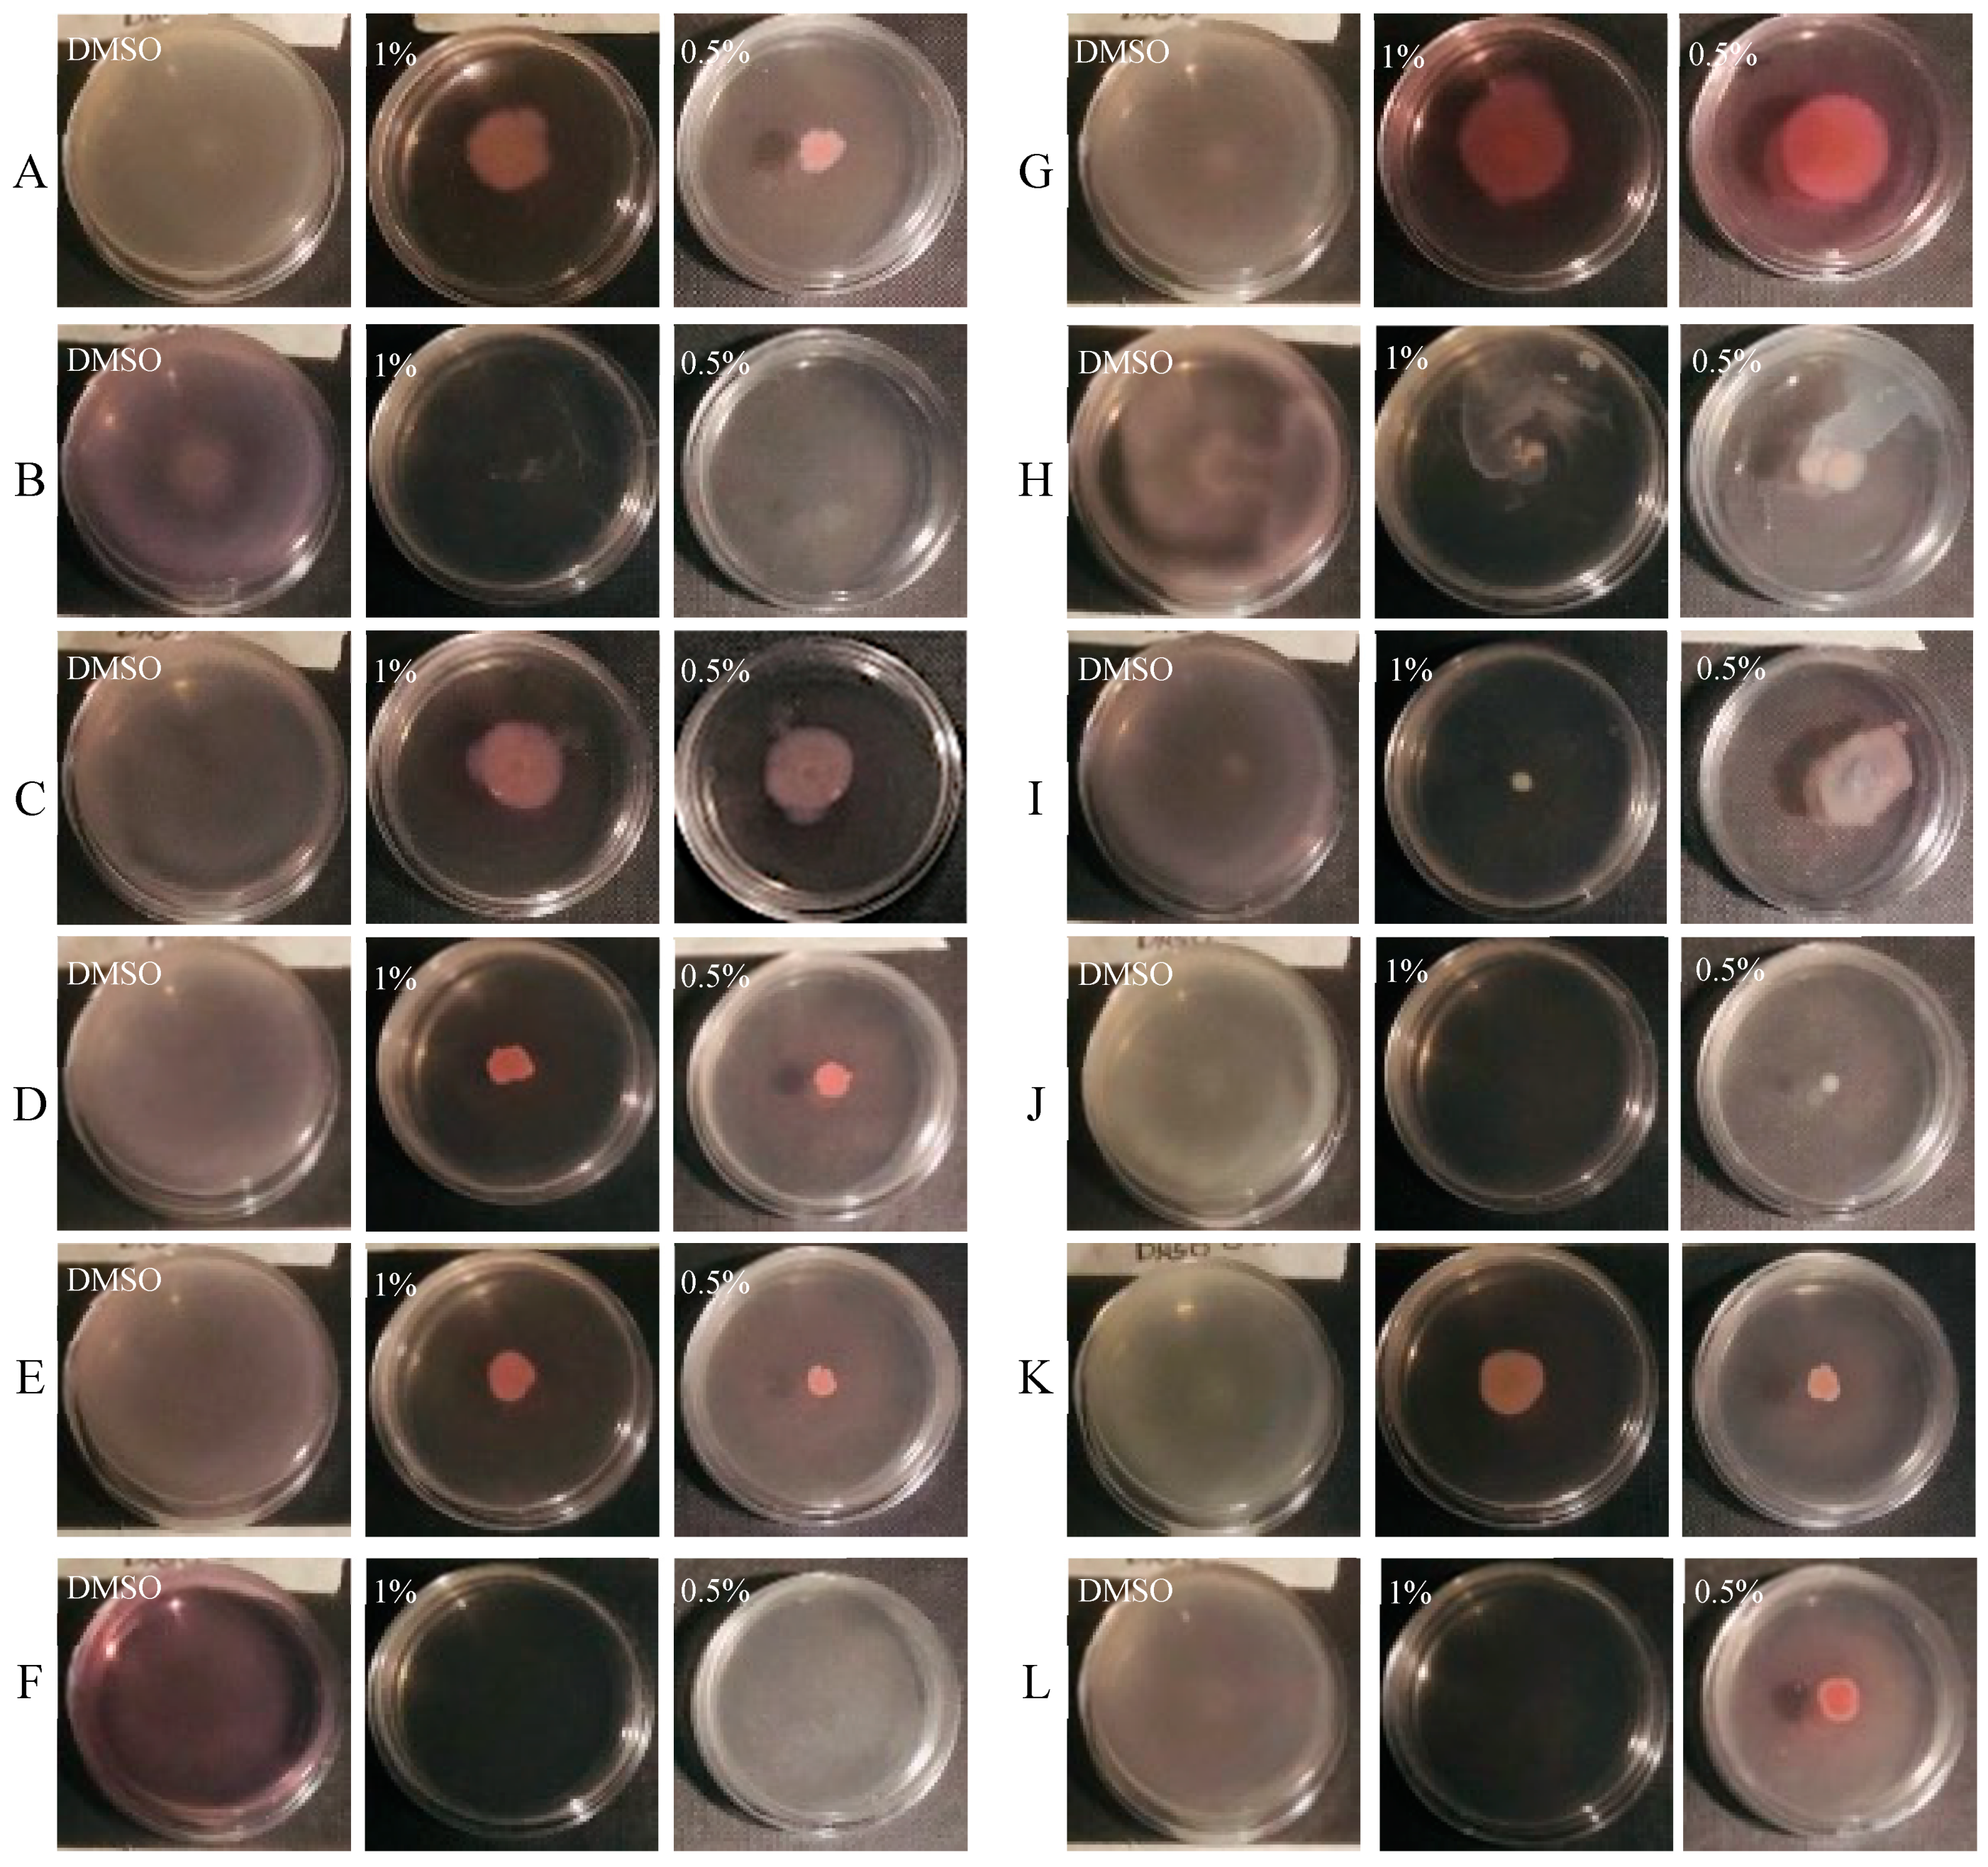

Anti-Virulence Properties of Coridothymus capitatus Essential Oil against Pseudomonas aeruginosa Clinical Isolates from Cystic Fibrosis Patients
Abstract
:1. Introduction
2. Materials and Methods
2.1. Ethics Approval and Informed Consent
2.2. Bacterial Strains and Growth Conditions
2.3. CCEO
2.4. Determination of Minimal Inhibitory Concentrations
2.5. Biofilm Formation Assays
2.5.1. Pre-Adhesion Period
2.5.2. Mature Biofilm
2.6. Pyocyanin Assay
2.7. Motility Assays
2.7.1. Swarming Assay
2.7.2. Swimming Assay
2.8. SEM Analysis
2.9. Statistical Analysis of Biological Evaluation
3. Results
3.1. Phenotypic Characterization of Clinical and PA14 Strains
3.2. Effect of EO on Biofilm Formation
3.3. Effect of CCEO on Pyocyanin Production
3.4. Effect of CCEO on Motility
3.5. SEM Analysis
3.5.1. Evaluation of the Effect of CCEO on P. aeruginosa PA14
3.5.2. Evaluation of the Effect of CCEO on P. aeruginosa 31P
4. Discussion
5. Conclusions
Supplementary Materials
Author Contributions
Funding
Institutional Review Board Statement
Informed Consent Statement
Data Availability Statement
Conflicts of Interest
References
- Gellatly, S.L.; Hancock, R.E.W. Pseudomonas aeruginosa: New insights into pathogenesis and host defenses. Pathog. Dis. 2013, 67, 159–173. [Google Scholar] [CrossRef] [PubMed] [Green Version]
- Castillo-Juárez, I.; López-Jacome, L.E.; Soberón-Chávez, G.; Tomas, M.; Lee, J.; Castañeda-Tamez, P.; Hernández-Bárragan, I.Á.; Cruz-Muniz, M.; Maeda, T.; Wood, T.K.; et al. Exploiting Quorum Sensing Inhibition for the Control of Pseudomonas aeruginosa and Acinetobacter baumannii Biofilms. Curr. Top. Med. Chem. 2017, 17, 1915–1927. [Google Scholar] [CrossRef]
- Edmondson, C.; Course, C.W.; Doull, I. Cystic fibrosis transmembrane conductance regulator modulators for cystic fibrosis: A new dawn? Arch. Dis. Child. 2021, 106, 941–945. [Google Scholar] [CrossRef] [PubMed]
- Rimessi, A.; Vitto, V.A.M.; Patergnani, S.; Pinton, P. Update on Calcium Signaling in Cystic Fibrosis Lung Disease. Front. Pharmacol. 2021, 12, 581645. [Google Scholar] [CrossRef] [PubMed]
- Rosales-Reyes, R.; Vargas-Roldán, S.Y.; Lezana-Fernández, J.L.; Santos-Preciado, J.I. Pseudomonas Aeruginosa: Genetic Adaptation, A Strategy for its Persistence in Cystic Fibrosis. Arch. Med. Res. 2021, 52, 357–361. [Google Scholar] [CrossRef] [PubMed]
- O’Sullivan, B.P.; Freedman, S.D. Cystic fibrosis. Lancet 2009, 373, 1891–1904. [Google Scholar] [CrossRef]
- Sousa, A.M.; Pereira, M.O. Pseudomonas aeruginosa Diversification during Infection Development in Cystic Fibrosis Lungs—A Review. Pathogens 2014, 3, 680–703. [Google Scholar] [CrossRef] [PubMed] [Green Version]
- Winstanley, C.; O’Brien, S.; Brockhurst, M. Pseudomonas aeruginosa Evolutionary Adaptation and Diversification in Cystic Fibrosis Chronic Lung Infections. Trends Microbiol. 2016, 24, 327–337. [Google Scholar] [CrossRef] [Green Version]
- Jurado-Martín, I.; Sainz-Mejías, M.; McClean, S. Pseudomonas aeruginosa: An Audacious Pathogen with an Adaptable Arsenal of Virulence Factors. Int. J. Mol. Sci. 2021, 22, 3128. [Google Scholar] [CrossRef]
- Bragonzi, A.; Paroni, M.; Nonis, A.; Cramer, N.; Montanari, S.; Rejman, J.; Di Serio, C.; Döring, G.; Tümmler, B. Pseudo-monas aeruginosa microevolution during cystic fibrosis lung infection establishes clones with adapted virulence. Am. J. Respir. Crit. Care Med. 2009, 180, 138–145. [Google Scholar] [CrossRef]
- Klockgether, J.; Cramer, N.; Fischer, S.; Wiehlmann, L.; Tümmler, B. Long-Term Microevolution of Pseudomonas aeruginosa Differs between Mildly and Severely Affected Cystic Fibrosis Lungs. Am. J. Respir. Cell Mol. Biol. 2018, 59, 246–256. [Google Scholar] [CrossRef] [PubMed]
- Pejčić, M.; Stojanović-Radić, Z.; Genčić, M.; Dimitrijević, M.; Radulović, N. Anti-virulence potential of basil and sage es-sential oils: Inhibition of biofilm formation, motility and pyocyanin production of Pseudomonas aeruginosa isolates. Food Chem. Toxicol. 2020, 141, 111431. [Google Scholar] [CrossRef]
- Wang, S.; Yu, S.; Zhang, Z.; Wei, Q.; Yan, L.; Ai, G.; Liu, H.; Ma, L.Z. Coordination of Swarming Motility, Biosurfactant Synthesis, and Biofilm Matrix Exopolysaccharide Production in Pseudomonas aeruginosa. Appl. Environ. Microbiol. 2014, 80, 6724–6732. [Google Scholar] [CrossRef] [Green Version]
- O’May, C.; Tufenkji, N. The Swarming Motility of Pseudomonas aeruginosa Is Blocked by Cranberry Proanthocyanidins and Other Tannin-Containing Materials. Appl. Environ. Microbiol. 2011, 77, 3061–3067. [Google Scholar] [CrossRef] [PubMed] [Green Version]
- Lee, K.; Yoon, S.S. Pseudomonas aeruginosa Biofilm, a Programmed Bacterial Life for Fitness. J. Microbiol. Biotechnol. 2017, 27, 1053–1064. [Google Scholar] [CrossRef] [PubMed] [Green Version]
- Zhou, J.; Bi, S.; Chen, H.; Chen, T.; Yang, R.; Li, M.; Fu, Y.; Jia, A.-Q. Anti-Biofilm and Antivirulence Activities of Metabolites from Plectosphaerella cucumerina against Pseudomonas aeruginosa. Front. Microbiol. 2017, 8, 769. [Google Scholar] [CrossRef] [PubMed] [Green Version]
- Alatraktchi, F.A.; Svendsen, W.E.; Molin, S. Electrochemical detection of pyocyanin as a biomarker for Pseudomonas aeru-ginosa: A focused review. Sensors 2020, 20, 5218. [Google Scholar] [CrossRef] [PubMed]
- Schauder, S.; Bassler, B.L. The languages of bacteria. Genes Dev. 2001, 15, 1468–1480. [Google Scholar] [CrossRef] [Green Version]
- Sheng, J.-Y.; Chen, T.-T.; Tan, X.-J.; Chen, T.; Jia, A.-Q. The quorum-sensing inhibiting effects of stilbenoids and their potential structure–activity relationship. Bioorganic Med. Chem. Lett. 2015, 25, 5217–5220. [Google Scholar] [CrossRef] [PubMed]
- Maisuria, V.B.; Santos, Y.L.-D.L.; Tufenkji, N.; Déziel, E. Cranberry-derived proanthocyanidins impair virulence and inhibit quorum sensing of Pseudomonas aeruginosa. Sci. Rep. 2016, 6, 30169. [Google Scholar] [CrossRef] [PubMed] [Green Version]
- Rasko, D.A.; Sperandio, V. Anti-virulence strategies to combat bacteria-mediated disease. Nat. Rev. Drug Discov. 2010, 9, 117–128. [Google Scholar] [CrossRef] [PubMed]
- Pattnaik, S.; Ahmed, T.; Ranganathan, S.K.; Ampasala, D.R.; Sarma, V.V.; Busi, S. Aspergillus ochraceopetaliformis SSP13 modulates quorum sensing regulated virulence and biofilm formation in Pseudomonas aeruginosa PAO1. Biofouling 2018, 34, 410–425. [Google Scholar] [CrossRef] [PubMed]
- Papa, R.; Selan, L.; Parrilli, E.; Tilotta, M.; Sannino, F.; Feller, G.; Tutino, M.L.; Artini, M. Anti-Biofilm Activities from Marine Cold Adapted Bacteria Against Staphylococci and Pseudomonas aeruginosa. Front. Microbiol. 2015, 6, 1333. [Google Scholar] [CrossRef] [PubMed] [Green Version]
- Koh, C.-L.; Sam, C.-K.; Yin, W.-F.; Tan, L.Y.; Krishnan, T.; Chong, Y.M.; Chan, K.-G. Plant-Derived Natural Products as Sources of Anti-Quorum Sensing Compounds. Sensors 2013, 13, 6217–6228. [Google Scholar] [CrossRef] [Green Version]
- Ceylan, O.; Sahin, M.D.; Akdamar, G. Antioxidant and Anti-quorum Sensing Potential of Acer monspessulanum subsp. monspessulanum Extracts. Planta Medica 2016, 82, 1335–1340. [Google Scholar] [CrossRef] [PubMed] [Green Version]
- Hentzer, M.; Givskov, M. Pharmacological inhibition of quorum sensing for the treatment of chronic bacterial infections. J. Clin. Investig. 2003, 112, 1300–1307. [Google Scholar] [CrossRef] [PubMed]
- Elmanama, A.A.; Al-Reefi, M.R. Antimicrobial, anti-biofilm, anti- quorum sensing, antifungal and synergistic effects of some medicinal plants extracts. IUG J. Nat. Eng. Stud. 2017, 25, 198–207. [Google Scholar]
- Zhang, J.; Rui, X.; Wang, L.; Guan, Y.; Sun, X.; Dong, M. Polyphenolic extract from Rosa rugosa tea inhibits bacterial quorum sensing and biofilm formation. Food Control. 2014, 42, 125–131. [Google Scholar] [CrossRef]
- Olivero-Verbel, J.; Barreto-Maya, A.; Bertel-Sevilla, A.; Stashenko, E.E. Composition, anti-quorum sensing and antimicrobial activity of essential oils from Lippia alba. Braz. J. Microbiol. 2014, 45, 759–767. [Google Scholar] [CrossRef] [Green Version]
- Skogman, M.E.; Kanerva, S.; Manner, S.; Vuorela, P.M.; Fallarero, A. Flavones as Quorum Sensing Inhibitors Identified by a Newly Optimized Screening Platform Using Chromobacterium violaceum as Reporter Bacteria. Molecules 2016, 21, 1211. [Google Scholar] [CrossRef] [Green Version]
- Ouyang, J.; Sun, F.; Feng, W.; Sun, Y.; Qiu, X.; Xiong, L.; Liu, Y.; Chen, Y. Quercetin is an effective inhibitor of quorum sensing, biofilm formation and virulence factors in Pseudomonas aeruginosa. J. Appl. Microbiol. 2016, 120, 966–974. [Google Scholar] [CrossRef] [PubMed] [Green Version]
- Kalia, M.; Yadav, V.K.; Singh, P.K.; Sharma, D.; Pandey, H.; Narvi, S.S.; Agarwal, V. Effect of cinnamon oil on quorum sens-ing-controlled virulence factors and biofilm formation in Pseudomonas aeruginosa. PLoS ONE 2015, 10, e0135495. [Google Scholar] [CrossRef] [PubMed] [Green Version]
- Artini, M.; Patsilinakos, A.; Papa, R.; Božović, M.; Sabatino, M.; Garzoli, S. Antimicrobial and antibiofilm activity and machine learning classification analysis of essential oils from different Mediterranean plants against Pseudomonas aeruginosa. Molecules 2018, 23, 482. [Google Scholar] [CrossRef] [Green Version]
- Patsilinakos, A.; Artini, M.; Papa, R.; Sabatino, M.; Bozovic, M.; Garzoli, S.; Vrenna, G.; Buzzi, R.; Manfredini, S.; Selan, L.; et al. Machine learning analyses on data in-cluding essential oil chemical composition and in vitro experimental antibiofilm activities against Staphylococcus species. Molecules 2019, 24, 890. [Google Scholar] [CrossRef] [PubMed] [Green Version]
- Ragno, R.; Papa, R.; Patsilinakos, A.; Vrenna, G.; Garzoli, S.; Tuccio, V.; Fiscarelli, E.; Selan, L.; Artini, M. Essential oils against bacterial isolates from cystic fibrosis patients by means of antimicrobial and unsupervised machine learning approaches. Sci. Rep. 2020, 10, 2653. [Google Scholar] [CrossRef] [PubMed]
- Papa, R.; Garzoli, S.; Vrenna, G.; Sabatino, M.; Sapienza, F.; Relucenti, M.; Donfrancesco, O.; Fiscarelli, E.V.; Artini, M.; Selan, L.; et al. Essential Oils Biofilm Modulation Activity, Chemical and Machine Learning Analysis. Application on Staphylococcus aureus Isolates from Cystic Fibrosis Patients. Int. J. Mol. Sci. 2020, 21, 9258. [Google Scholar] [CrossRef] [PubMed]
- Kordali, S.; Cakir, A.; Ozer, H.; Cakmakci, R.; Kesdek, M.; Mete, E. Antifungal, phytotoxic and insecticidal properties of essential oil isolated from Turkish Origanum acutidens and its three components, carvacrol, thymol and p-cymene. Bioresour. Technol. 2008, 99, 8788–8795. [Google Scholar] [CrossRef]
- Zaïri, A.; Nouir, S.; Khalifa, M.A.; Ouni, B.; Haddad, H.; Khelifa, A.; Trabelsi, M. Phytochemical analysis and assessment of bio-logical properties of essential oils obtained from thyme and Rosmarinus species. Curr. Pharm. Biotechnol. 2020, 21, 414–424. [Google Scholar] [CrossRef]
- Moumni, S.; Elaissi, A.; Trabelsi, A.; Merghni, A.; Chraief, I.; Jelassi, B.; Chemli, R.; Ferchichi, S. Correlation between chemical composition and antibacterial activity of some Lamiaceae species essential oils from Tunisia. BMC Complement. Med. Ther. 2020, 20, 103. [Google Scholar] [CrossRef] [Green Version]
- Humphries, R.M.; Ambler, J.; Mitchell, S.L.; Castanheira, M.; Dingle, T.; Hindler, J.A.; Koeth, L.; Sei, K.; Hardy, D.; Zimmer, B.; et al. CLSI methods development and standardization working group best practices for evaluation of antimicrobial susceptibility tests. J. Clin. Microbiol. 2018, 56, 10. [Google Scholar] [CrossRef] [PubMed] [Green Version]
- Yang, R.; Guan, Y.; Zhou, J.; Sun, B.; Wang, Z.; Chen, H.; He, Z.; Jia, A. Phytochemicals from Camellia nitidissima Chi Flowers Reduce the Pyocyanin Production and Motility of Pseudomonas aeruginosa PAO1. Front. Microbiol. 2018, 8, 2640. [Google Scholar] [CrossRef] [PubMed] [Green Version]
- Bossù, M.; Selan, L.; Artini, M.; Relucenti, M.; Familiari, G.; Papa, R.; Vrenna, G.; Spigaglia, P.; Barbanti, F.; Salucci, A.; et al. Characterization of Scardovia wiggsiae Biofilm by Original Scanning Electron Microscopy Protocol. Microorganisms 2020, 8, 807. [Google Scholar] [CrossRef]
- Relucenti, M.; Familiari, G.; Donfrancesco, O.; Taurino, M.; Li, X.; Chen, R.; Artini, M.; Papa, R.; Selan, L. Microscopy Methods for Biofilm Imaging: Focus on SEM and VP-SEM Pros and Cons. Biology 2021, 10, 51. [Google Scholar] [CrossRef] [PubMed]
- Relucenti, M.; Miglietta, S.; Bove, G.; Donfrancesco, O.; Battaglione, E.; Familiari, P.; Barbaranelli, C.; Covelli, E.; Barbara, M.; Familiari, G. SEM BSE 3D Image Analysis of Human Incus Bone Affected by Cholesteatoma Ascribes to Osteoclasts the Bone Erosion and VpSEM dEDX Analysis Reveals New Bone Formation. Scanning 2020, 2020, 9371516. [Google Scholar] [CrossRef] [PubMed] [Green Version]
- Choi, J.Y.; Sifri, C.; Goumnerov, B.C.; Rahme, L.G.; Ausubel, F.M.; Calderwood, S.B. Identification of Virulence Genes in a Pathogenic Strain of Pseudomonas aeruginosa by Representational Difference Analysis. J. Bacteriol. 2002, 184, 952–961. [Google Scholar] [CrossRef] [PubMed] [Green Version]
- Mikkelsen, H.; McMullan, R.; Filloux, A. The Pseudomonas aeruginosa Reference Strain PA14 Displays Increased Virulence Due to a Mutation in ladS. PLoS ONE 2011, 6, e29113. [Google Scholar] [CrossRef] [PubMed] [Green Version]
- Bakkali, F.; Averbeck, S.; Averbeck, D.; Idaomar, M. Biological effects of essential oils-a review. Food Chem. Toxicol. 2008, 46, 446–475. [Google Scholar] [CrossRef] [PubMed]
- Pesavento, G.; Maggini, V.; Maida, I.; Nostro, A.L.; Calonico, C.; Sassoli, C.; Perrin, E.; Fondi, M.; Mengoni, A.; Chiellini, C.; et al. Essential Oil from Origanum vulgare Completely Inhibits the Growth of Multidrug-Resistant Cystic Fibrosis Pathogens. Nat. Prod. Commun. 2016, 11, 861–864. [Google Scholar] [CrossRef] [PubMed]
- Price-Whelan, A.; Dietrich, L.E.; Newman, D.K. Rethinking ’secondary’ metabolism: Physiological roles for phenazine an-tibiotics. Nat. Chem. Biol. 2006, 2, 71–78. [Google Scholar] [CrossRef]
- O’Malley, C.A. Infection Control in Cystic Fibrosis: Cohorting, Cross-Contamination, and the Respiratory Therapist. Respir. Care 2009, 54, 641–657. [Google Scholar] [CrossRef]
- El-Sayed, N.; Samir, R.; Abdel-Hafez, L.J.M.; Ramadan, M. Olive Leaf Extract Modulates Quorum Sensing Genes and Biofilm Formation in Multi-Drug Resistant Pseudomonas aeruginosa. Antibiotics 2020, 9, 526. [Google Scholar] [CrossRef] [PubMed]
- Tapia-Rodriguez, M.R.; Bernal-Mercado, A.T.; Gutierrez-Pacheco, M.M.; Vazquez-Armenta, F.J.; Hernandez-Mendoza, A.; Gonzalez-Aguilar, G.A.; Martinez-Tellez, M.A.; Nazzaro, F.; Ayala-Zavala, J.F. Virulence of Pseudomonas aeruginosa exposed to carvacrol: Alterations of the Quorum sensing at enzymatic and gene levels. J. Cell Commun. Signal. 2019, 13, 531–537. [Google Scholar] [CrossRef] [PubMed]
- Cáceres, M.; Hidalgo, W.; Stashenko, E.; Torres, R.; Ortiz, C. Essential Oils of Aromatic Plants with Antibacterial, Anti-Biofilm and Anti-Quorum Sensing Activities against Pathogenic Bacteria. Antibiotics 2020, 9, 147. [Google Scholar] [CrossRef] [PubMed] [Green Version]
- O’Malley, Y.Q.; Reszka, K.J.; Rasmussen, G.T.; Abdalla, M.Y.; Denning, G.M.; Britigan, B.E. The Pseudomonas secretory product pyocyanin inhibits catalase activity in human lung epithelial cells. Am. J. Physiol. Lung Cell Mol. Physiol. 2003, 285, L1077–L1086. [Google Scholar] [CrossRef] [PubMed] [Green Version]

| Chemical Component | Peak Area (%) |
|---|---|
| Carvacrol | 61.0 |
| β-caryophyllene | 13.6 |
| p-cymene | 7.1 |
| γ-terpinene | 6.0 |
| Linalool | 1.8 |
| β-bisabolene | 1.6 |
| β-myrcene | 1.6 |
| α-terpinene | 1.5 |
| caryophyllene oxide | 1.4 |
| α-thujene | 1.0 |
| 1-octen-3-ol | 0.7 |
| Borneol | 0.6 |
| Humulene | 0.6 |
| Thymol | 0.5 |
| Limonene | 0.3 |
| β-phellandrene | 0.3 |
| cis- β-terpineol | 0.2 |
| α-citral | 0.2 |
| Total (%) | 100 |
| Bacterial Strain | Pyocyanin (OD 520 nm) | Biofilm a (OD 590 nm) | Biofilm b (OD 590 nm) | Swarming Motility c | Swimming Motility c |
|---|---|---|---|---|---|
| PA14 | 0.178 ± 0.042 | 3.561 ± 0.357 | 13.470 ± 1.403 | +++ | +++ |
| 23P | 0.148 ± 0.024 | 3.175 ± 0.851 | 0.738 ± 0.373 | +++ | +++ |
| 26P | 0.120 ± 0.024 | 0.656 ± 0.281 | 2.107 ± 1.182 | +++ | +++ |
| 27P | 0.102 ± 0.005 | 1.429 ± 0.643 | 3.049 ± 0.796 | +++ | +++ |
| 28P | 0.093 ± 0.032 | 0.265 ± 0.038 | 2.540 ± 0.799 | +++ | +++ |
| 29P | 0.199 ± 0.059 | 0.294 ± 0.066 | 10.432 ± 3.483 | +++ | +++ |
| 30P | 0.115 ± 0.022 | 0.866 ± 0.345 | 5.013 ± 1.391 | +++ | +++ |
| 31P | 0.063 ± 0.031 | 1.741 ± 0.154 | 5.133 ± 0.946 | +++ | +++ |
| 32P | 0.121 ± 0.037 | 1.117 ± 0.163 | 5.597 ± 1.390 | +++ | +++ |
| 33P | 0.050 ± 0.033 | 0.656 ± 0.115 | 4.148 ± 1.173 | +++ | +++ |
| 34P | 0.094 ± 0.031 | 1.024 ± 0.212 | 3.072 ± 0.611 | +++ | +++ |
| 40P | 0.160 ± 0.041 | 0.970 ± 0.201 | 2.172 ± 0.194 | +++ | +++ |
| Bacterial Strain | Percentage of Pyocyanin Production |
|---|---|
| PA14 | 7% |
| 23P | 0% |
| 26P | 0% |
| 27P | 0% |
| 28P | 0% |
| 29P | 0% |
| 30P | 0% |
| 31P | 0% |
| 32P | 16% |
| 33P | 2% |
| 34P | 0% |
| 40P | 7% |
Publisher’s Note: MDPI stays neutral with regard to jurisdictional claims in published maps and institutional affiliations. |
© 2021 by the authors. Licensee MDPI, Basel, Switzerland. This article is an open access article distributed under the terms and conditions of the Creative Commons Attribution (CC BY) license (https://creativecommons.org/licenses/by/4.0/).
Share and Cite
Vrenna, G.; Artini, M.; Ragno, R.; Relucenti, M.; Fiscarelli, E.V.; Tuccio Guarna Assanti, V.; Papa, R.; Selan, L. Anti-Virulence Properties of Coridothymus capitatus Essential Oil against Pseudomonas aeruginosa Clinical Isolates from Cystic Fibrosis Patients. Microorganisms 2021, 9, 2257. https://doi.org/10.3390/microorganisms9112257
Vrenna G, Artini M, Ragno R, Relucenti M, Fiscarelli EV, Tuccio Guarna Assanti V, Papa R, Selan L. Anti-Virulence Properties of Coridothymus capitatus Essential Oil against Pseudomonas aeruginosa Clinical Isolates from Cystic Fibrosis Patients. Microorganisms. 2021; 9(11):2257. https://doi.org/10.3390/microorganisms9112257
Chicago/Turabian StyleVrenna, Gianluca, Marco Artini, Rino Ragno, Michela Relucenti, Ersilia Vita Fiscarelli, Vanessa Tuccio Guarna Assanti, Rosanna Papa, and Laura Selan. 2021. "Anti-Virulence Properties of Coridothymus capitatus Essential Oil against Pseudomonas aeruginosa Clinical Isolates from Cystic Fibrosis Patients" Microorganisms 9, no. 11: 2257. https://doi.org/10.3390/microorganisms9112257
APA StyleVrenna, G., Artini, M., Ragno, R., Relucenti, M., Fiscarelli, E. V., Tuccio Guarna Assanti, V., Papa, R., & Selan, L. (2021). Anti-Virulence Properties of Coridothymus capitatus Essential Oil against Pseudomonas aeruginosa Clinical Isolates from Cystic Fibrosis Patients. Microorganisms, 9(11), 2257. https://doi.org/10.3390/microorganisms9112257

